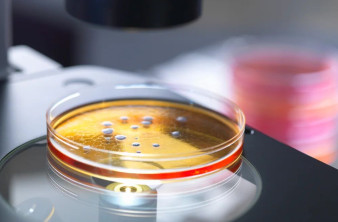
Alt text

EDITOR OF TECHGEAR
Christos Elpidis
Το ταξίδι ξεκίνησε από έναν Atari ST 520 στα '80s για μια μακρά περίοδο καψίματος στο gaming με το Kick Off 2 (αν είχε eSports τότε θα ήμουν εκατομμυριούχος...) και τα κλασικά adventures. Μετά ήρθαν τα PCs, το Internet, τα MP3s, τα Mac, τα κινητά, τα smartphones και όλα τα μαραφέτια που ορίζουν την καθημερινότητα μας σήμερα.